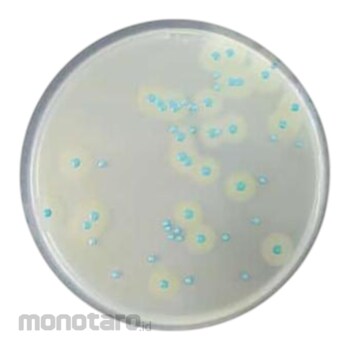
main product photo

Biokar COMPASS Listeria Agar Base BK192HA 500g 1pc
Rp9.299.900
Persediaan
Spesifikasi Produk
| Model Number | BK192HA |
|---|---|
| Unit | 1pc |
| format | Dehydrated Culture Media |
| Product Type | Consumables |
| Packaging Size (g) | 500 |
| Berat (Kg) | 2.0 |
| Tanggal Produk Terdaftar | 14 July 2025 |
| Terakhir Diperbaharui | 15 July 2025 |
Informasi Produk
Description
Biokar COMPASS LISTERIA AGAR (BASE) 500g BK192HA
Ketentuan dan Kondisi Barang
COD Tidak Berlaku
Pembayaran COD tidak tersedia untuk produk ini. Lihat selengkapnya
Pengembalian Barang 14 hari
Berubah pikiran tidak dapat diterima. Lihat selengkapnya
GRATIS ONGKIR* ke Jabodetabek, Banten,
Jabar & Jatim dengan minimum total pesanan Rp200.000 saat checkout. Lihat selengkapnya
Jabar & Jatim dengan minimum total pesanan Rp200.000 saat checkout. Lihat selengkapnya
Pilih jenis produk yang diinginkan
| Nomor SKU | Model Number | Masa Persiapan Barang | Harga | Jumlah |
|---|---|---|---|---|
| Loading... | ||||
Ulasan Produk
Tidak ada ulasan